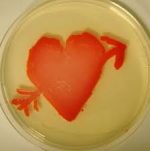

Happy Friday! This week’s Pandora Report covers progress on the ninth round of negotiations on a Pandemic Accord and proposed amendments to the International Health Regulations, Murthy v. Missouri and the evolving threat of health and medical misinformation, a recently launched Senate biodefense and life science research investigation, EPA’s warnings about cyberattacks against the United States’ water infrastructure and more.
Global Leaders Call for Urgent Agreement on a Pandemic Accord
More than 100 global leaders have made a call “to press for an urgent agreement from international negotiators on a Pandemic Accord, under the Constitution of the World Health Organization, to bolster the world’s collective preparedness and response to future pandemics,” according to a recent WHO press release. It comes as member states of the WHO look to finalize an agreement that would amend the 2005 International Health Regulations (IHR), which will be considered by the World Health Assembly in May. David P. Fidler explains what is at stake during this ninth round of deliberations in a recent piece for CFR’s Think Global Health, writing in part “WHO documents on the negotiations, along with commentary parsing the talks, indicate that WHO member states have much to do in a short period to deliver final drafts of a pandemic agreement and amended IHR to the World Health Assembly. Unresolved issues include problems that have long confounded global health governance, including equitable access to pharmaceutical products, financing for public health capacity-building, and government accountability. Even if the negotiations achieve breakthroughs on those problems, the task of turning reforms on paper into reality in practice confronts a world in which solidarity is increasingly in short supply.”
The letter challenges those who argue such amendments will harm national sovereignty, reading in part, “A new pandemic threat will emerge; there is no excuse not to be ready for it. It is thus imperative to build an effective, multisectoral, and multilateral approach to pandemic prevention, preparedness, and response. Given the unpredictable nature of public-health risks, a global strategy must embody a spirit of openness and inclusiveness. There is no time to waste, which is why we are calling on all national leaders to redouble their efforts to complete the accord by the May deadline.”
“Beyond protecting countless lives and livelihoods, the timely delivery of a global pandemic accord would send a powerful message: even in our fractured and fragmented world, international cooperation can still deliver global solutions to global problems.”
SCOTUS Hears Case Concerning Social Media Platforms, Pandemic Misinformation
The Supreme Court heard arguments this week in Murthy v. Missouri, a case concerning the First Amendment and whether the Biden administration violated the right to freedom of expression in its communications with social media companies regarding COVID-19-related misinformation. The lawsuit, one of 26 filed against the administration by former Missouri Attorney General Eric Schmitt, alleges that the Biden administration was “…working with social media giants such as Meta, Twitter, and YouTube to censor and suppress free speech, including truthful information, related to COVID-19, election integrity, and other topics, under the guise of combating ‘misinformation.”
NYT‘s Dani Blum explains how this has refocused attention on misinformation and its evolving nature, writing in part “Health hacks not backed by science have spread widely on social media platforms. The same kinds of conspiracy theories that helped to fuel vaccine hesitancy during the Covid-19 pandemic are now undermining trust in vaccines against other diseases, including measles, as more people have lost confidence in public health experts and institutions. And rapid developments in artificial intelligence have made it even harder for people to tell what’s true and what’s false online.”
Blum continues, writing “Misinformation commonly includes “fake experts,” according to Sander van der Linden, a professor of social psychology in society at Cambridge who researches misinformation. These are either people making health claims who do not have any medical credentials, or doctors making statements about topics that they are not experts in. “You wouldn’t want to go to an ear and nose doctor to do a heart operation,” he said. “Is this a vaccine expert, or is this a doctor who actually does no research and has no expertise on vaccinations?”’
The effects of this are being keenly felt by healthcare providers. Amanda Johnson, a primary care physician in New York City, told USA Today about her approach to working with patients who have fallen victim to such information, saying “(Frustration) doesn’t get us anywhere. I think those conversations are more likely to go poorly if you take it as a personal affront.”
The same article explains further that “She has talked about misinformation with patients, some of whom have even asked her to review social media posts they’ve seen. The most animated responses come from patients who believe they’re losing control or having something forced on them, said Johnson, who also leads NYC Health + Hospitals’ AfterCare program for New Yorkers recovering from COVID-19 or living with long COVID.”
“Many people are disparaging or dismissive when talking about people who believe misinformation, but it can happen to anyone, said Sedona Chinn, an assistant professor in the life sciences communication department at the University of Wisconsin-Madison.”
Senate Homeland Security and Governmental Affairs Committee Announces Bipartisan Biodefense and Life Science Research Investigation
In a statement this week, the Senate Homeland Security and Governmental Affairs Committee announced, “U.S. Senators Gary Peters (D-MI) and Rand Paul (R-KY), Chairman and Ranking Member of the Homeland Security and Governmental Affairs Committee, announced a joint investigation of national security threats posed by high-risk biological research and technology in the U.S. and abroad. Peters and Paul plan to hold hearings and conduct government-wide oversight on areas including high-risk life science research, biodefense, synthetic biology, biosafety and biosecurity lapses, early warning capabilities for emerging outbreaks or possible attacks, and potential origins of the COVID-19 pandemic. This bipartisan oversight effort will assess and identify measures to mitigate longstanding and emerging risks and threats that may result in serious biological incidents – whether deliberate, accidental, or natural. The investigation will also seek to increase transparency and strengthen oversight of taxpayer-funded life sciences research, laboratories in the U.S. and abroad, and detection of biological threats.”
This is likely to add fire to efforts to impose new restrictions on contracted Chinese research firms like WuXi AppTec, as highlighted by Axios. At the same time, this will likely further reveal partisan divides on the topic, particularly given Paul’s emphasis on the Biden administration’s alleged efforts to conceal critical information about the COVID-19 pandemic.
EPA Confirms China- and Iran-Backed Hackers Are Targeting US Drinking Water Systems
“The country’s water systems are being hit with an increasing number of nation-state cyberattacks, according to the US Environmental Protection Agency (EPA),” explains a recent news article. In a recent letter to governors from EPA Administrator Michael Regan and National Security Adviser Jake Sullivan, the pair wrote ‘“We need your support to ensure that all water systems in your state comprehensively assess their current cybersecurity practices.”’ They also emphasized that, in many cases, “even basic cybersecurity precautions, are not present at water treatment facilities, urging that this “can mean the difference between business as usual and a disruptive cyberattack.”
CNN reports that “The EPA will also set up a “task force” to “identify the most significant vulnerabilities of water systems to cyberattacks,” among other pressing issues, Regan and Sullivan said in their letter. The Biden officials invited state homeland security and environmental officials to a meeting to discuss cybersecurity improvements needed in the water sector.”
This comes after industrial equipment at multiple water facilities in the US was hacked late last year, displaying an anti-Israel message, according to US officials. The administration blamed the Iranian government for these attacks. Hackers backed by the Chinese state have also recently infiltrated US water facilities, in “…a hacking campaign that the Biden administration worries Beijing could use to disrupt critical infrastructure in the event of a conflict with the US. China denies the allegations.”
US Hosts Launch for New Foreign Ministry Channel for Global Health Security
Recently, the US Department of State announced that Ambassador John Nkengasong – U.S. Global AIDS Coordinator and Senior Bureau Official for Global Health Security and Diplomacy, overseeing the Department’s Bureau for Global Health Security and Diplomacy – hosted a day-long discussion program to help plan priorities and review lines of efforts for the recently created Foreign Ministry Channel for Global Health Security.
The Department’s press statement explains that “The Channel builds on the 2022-2023 COVID-19 Pandemic Prioritized Global Action Plan for Enhanced Engagement (GAP). The meeting is the first in a series of regular engagements between senior officials within Ministries of Foreign Affairs to focus diplomatic attention and action on critical global health security priorities. The foreign ministries, and participants from other ministries, will build on progress in this first meeting to elevate global health security issues as a national security imperative, enhance pandemic preparedness, and advance concrete global health security deliverables. Participants will collaborate on global efforts to:
- Strengthen pandemic prevention and early-warning capacities
- Address misinformation and disinformation on health issues, and leverage emerging technologies to strengthen global health security
- Mitigate the human health impacts of climate change utilizing the One Health approach, which recognizes the interconnectedness of human, animal, and environmental health
- Enable sustainable medical countermeasures for health emergencies
- Enhance diplomatic workforce capacity on health security.”

“‘Lab Leak’ Proponents at Rutgers Accused of Defaming and Intimidating COVID-19 Origin Researchers”
Jocelyn Kaiser covers a recent formal complaint filed with Rutgers University regarding the conduct of molecular biologist Richard Ebright and microbiologist Bryce Nickels, both employed by the university. Kaiser explains in the news piece for Science, “But now, their targets have had enough. A dozen scientists filed a formal complaint with Rutgers yesterday alleging that the two faculty members have violated the university’s policies on free expression by posting “provably false” comments that are often defamatory, and that some of their actions could even threaten scientists’ safety.”
Read more here.
“How to Better Research the Possible Threats Posed by AI-Driven Misuse of Biology”
Matthew E. Walsh recently authored this piece for The Bulletin of the Atomic Scientists, writing in part “Nonetheless, researchers have conducted experiments that aim to evaluate sub-components of biological threats—such as the ability to develop a plan for or obtain information that could enable misuse. Two recent efforts—by RAND Corporation and OpenAI—to understand how artificial intelligence could lower barriers to the development of biological weapons concluded that access to a large language model chatbot did not give users an edge in developing plans to misuse biology. But those findings are just one part of the story and should not be considered conclusive.”
“An Action Plan to Increase the Safety and Security of Advanced AI”
This action plan from Gladstone AI was completed following the release of an October 2022 State Department assessment of proliferation and security risks posed by weaponized and misaligned AI. The plan-“Defense in Depth: An Action Plan to Increase the Safety and Security of Advanced AI“-explains in part of its introduction that “This action plan is a blueprint for that intervention. Its aim is to increase the safety and security of advanced AI by countering catastrophic national security risks from AI weaponization and loss of control. It was developed over thirteen months, and informed by conversations with over two hundred stakeholders from across the U.S., U.K., and Canadian governments; major cloud providers; AI safety organizations; security and computing experts; and formal and informal contacts at the frontier AI labs themselves. The actions we propose follow a sequence that:
● Begins by establishing interim safeguards to stabilize advanced AI development,
including export controls on the advanced AI supply chain;
● Leverages the time gained to develop basic regulatory oversight and strengthen
U.S. government capacity for later stages;
● Transitions into a domestic legal regime of responsible AI development and
adoption, safeguarded by a new U.S. regulatory agency; and
● Extends that regime to the multilateral and international domains.”
“Government Commissioned Report: AI is Creating New Categories of Weapons of Mass Destruction”
This recent article in the Claims Journal covers the aforementioned report from the State Department focused on WMD threats and AI: “A U.S. State Department-commissioned report asserts that advanced artificial intelligence is creating entirely new categories of weapons of mass destruction-like (WMD-like) and WMD-enabling catastrophic…The risks associated with these developments are global, have deeply technical origins and are quickly evolving, leaving policymakers with diminishing opportunities to introduce safeguards to balance these considerations and ensure advanced AI is developed and adopted responsibly.”
Read more here.
“Why Are Large AI Models Being Red Teamed?”
Natasha Bajema covers AI red teaming in this piece for IEEE Spectrum, writing in part “In February, OpenAI announced the arrival of Sora, a stunning “text-to-video” tool. Simply enter a prompt, and Sora generates a realistic video within seconds. But it wasn’t immediately available to the public. Some of the delay is because OpenAI reportedly has a set of experts called a red team who, the company has said, will probe the model to understand its capacity for deepfake videos, misinformation, bias, and hateful content.”
“Red teaming, while having proved useful for cybersecurity applications, is a military tool that was never intended for widespread adoption by the private sector.”
‘“Done well, red teaming can identify and help address vulnerabilities in AI,” says Brian Chen, director of policy from the New York–based think tank Data & Society. “What it does not do is address the structural gap in regulating the technology in the public interest.”’
“Biodefense in the FY25 President’s Budget Request”
Lillian Parr and Dan Regan recently published this blog post with CSR’s Nolan Center in which they compare the FY25 budget request to the FY24 Continuing Resolution. They explain “On Monday, March 11, the Biden Administration released the President’s Budget Request (PBR) for Fiscal Year 2025. While the final budget appropriations bills enacted by Congress will likely differ substantially from this request, the PBR provides useful insight into the Administration’s priorities. This blog post will highlight a few notable funding lines and trends for biodefense-focused programs…The initial tranche of the PBR documents, namely the Budget of the United States Government and the budget-in-briefs from each agency, state the priority budget items and highlight significant changes in funding. This analysis is largely based on these highlights and the topline budget numbers available. Over the next several weeks the agencies will complete the release of their budget justification books, which contain the highest level of detail on budgetary resourcing. Once all of the final justification books are released, we’ll announce our updated CSR Biodefense Budget Breakdown.”
“Public Health Emergency Medical Countermeasures Enterprise Multiyear Budget: Fiscal Years 2023-2027”
ASPR recently released the Public Health Emergency Medical Countermeasure Enterprise (PHEMCE) Multiyear Budget (MYB) for fiscal years 2023-2027. “The report assesses funding needs to support medical countermeasure priorities, which would allow the U.S. Government to prepare for the next public health threat. The MYB projects an estimated overall funding need of $79.5 billion over the five-year period, an increase of $15.5 billion over the 2022-2026 report. The MYB is not a budget request and does not replace funding levels requested in the President’s Budget or accompanying documents.”
“The MYB forecasts to Congress and external stakeholders the funding required to fully prepare the country for a range of chemical, biological, radiological, and nuclear threats, without regard to the competing priorities considered in the President’s Budget. The MYB also illustrates the support needed for other key priorities — such as supporting innovative approaches to medical countermeasure (MCM) development and fostering clear, scientifically supported regulatory pathways for MCMs.”
“Ready or Not 2024: Protecting the Public’s Health from Diseases, Disasters, and Bioterrorism”
From Trust for America’s Health: “As the nation experiences an increasing number of infectious disease outbreaks and extreme weather events, TFAH’s Ready or Not 2024: Protecting the Public’s Health from Diseases, Disasters, and Bioterrorism report identifies key gaps in national and state preparedness to protect residents’ health during emergencies and makes recommendations to strengthen the nation’s public health system and improve emergency readiness.”
“Op-Ed: Proposed LDTs Rule Threatens Outbreak Containment”
Linoj Samuel and Erin Graf, Chair and Vice Chair of the American Society for Microbiology’s Clinical and Public Health Microbiology Committee respectively, recently authored this opinion piece discussing how federal regulations currently under consideration might harm the effectiveness of of laboratory-developed tests for fast-moving outbreaks. They write in part, “The Food and Drug Administration (FDA) recently proposed a rule that would require the same premarket approval for LDTs as it does for medical devices, such as prosthetic joints or pacemakers. The potential rule could bring significant harm to patients by limiting the clinical microbiology and public health laboratories that serve them. The medical device pathway under consideration is designed for commercially developed medical devices. It’s ill-suited to regulate LDTs, and it’s especially at odds with the realities of infectious disease testing. If adopted, the FDA’s rule will disincentivize clinical and public health labs from developing and deploying essential LDTs. It will create gaps in diagnosis and care, and it could potentially impact underserved communities the most.”
“Clinical, Biomarker, and Research Tests Among US Government Personnel and Their Family Members Involved in Anomalous Health Incidents”
Chan, Hallett, and Zalewski recently published this article in JAMA: “Questions Do US government officials and their family members involved in anomalous health incidents (AHIs) differ from control participants with respect to clinical, biomarker, and research assessments?”
“Findings In this exploratory study that included 86 participants reporting AHIs and 30 vocationally matched control participants, there were no significant differences in most tests of auditory, vestibular, cognitive, visual function, or blood biomarkers between the groups. Participants with AHIs performed significantly worse on self-reported and objective measures of balance, and had significantly increased symptoms of fatigue, posttraumatic stress disorder, and depression compared with the control participants; 24 participants (28%) with AHIs presented with functional neurological disorders.”
“Meaning In this exploratory study, there were no significant differences between individuals reporting AHIs and matched control participants with respect to most clinical, research, and biomarker measures, except for self-reported and objective measures of imbalance; symptoms of fatigue, posttraumatic stress, and depression; and the development of functional neurological disorders in some.”
“Russia Appears to Be Using Chemical Weapons in Ukraine. And Admitting It.”
Matt Field covers the debate over the validity of Ukraine’s claims that Russia is using CW in the ongoing war in Ukraine for The Bulletin of the Atomic Scientists, writing in part “For Lennie Phillips, a former inspector for the Organisation for the Prohibition of Chemical Weapons (OPCW), which implements the Chemical Weapons Convention, some of Ukraine’s claims appear credible, including a segment on Russian state-controlled TV that included an interview with a man the US embassy in The Hague reports is a Russian soldier discussing the effectiveness of chemicals as weapons. “The piece on Russia’s Channel [One] alone makes the use of tear gas by the [Russian Federation] very credible,” Phillips, now a research fellow at the UK defense think tank RUSI, said.”
“The Centre for Chemistry and Technology and the Future of the OPCW”
Ian Anthony recently published this paper with the Stockholm International Peace Research Institute: “With the destruction of the final remaining stockpiles of declared chemical weapons in 2023, the Organisation for the Prohibition of Chemical Weapons (OPCW) must adjust to a new role. The inauguration of the OPCW’s Centre for Chemistry and Technology (CCT) in 2023 provides a new resource to assist the organization and the international community in reducing and eliminating the threat from chemical weapons.”
“Now that the CCT is operational, it is important to build momentum behind a substantive programme of work. Projects for the programme could be grouped into four thematic categories: understanding technological developments; chemical forensics; broadening geographical representation; and tailored training programmes.”
“The CCT should be led by a director, who should work with a newly established Office of Science and Technology to develop the centre’s strategic direction. To provide the CCT with stable and secure financing, a trust fund for the CCT should be established.”

Report Release Webinar: Future State of Smallpox Medical Countermeasures
From National Academies of Science and Medicine: “Join the Committee on Current State of Research, Development, and Stockpiling of Smallpox Medical Countermeasures as it discusses its newly released report Future State of Smallpox Medical Countermeasures on Tuesday, March 26, 2024.”
Learn more and join the discussion here.
Artificial Intelligence and Automated Laboratories for Biotechnology: Leveraging Opportunities and Mitigating Risks
From the National Academies’ Board on Life Sciences: “Please join us April 3-4, 2024 for a hybrid workshop on the opportunities and mitigation of risks of the use of artificial intelligence and automated laboratories (i.e., self-driving labs) for biotechnology.”
“The workshop will consider opportunities to leverage AI and laboratory automation capabilities for discovery and development, explore methods and approaches to identify, track, and forecast the domestic and international development of such technologies, and convene experts across sectors to highlight recent advances and explore implications for the development and use of these technologies.”
Learn more and register here.
Launch of the 2024 National Blueprint on Biodefense
From the Bipartisan Commission on Biodefense: “On the 10th anniversary of its inception, the Bipartisan Commission on Biodefense will release its 2024 National Blueprint on Biodefense: Immediate Action Needed to Defend Against Biological Threats.”
“Please join us for this momentous event at the Congressional Auditorium, Capitol Visitor Center, on April 17th at 4:30pm.”
“The Bipartisan Commission on Biodefense (formerly the Blue Ribbon Study Panel on Biodefense) was established in 2014 to provide a comprehensive assessment of the state of United States biodefense efforts and to issue recommendations that foster change. Subsequently, the Commission has briefed White House Administrations (including then Vice President Biden); testified before Congress; convened numerous meetings with experts; released 12 reports; produced the graphic novel Germ Warfare; and mobilized biodefense conversations and actions in the private and public sectors.”
Learn more and register here.
Addressing the Challenges Posed by Chemical and Biological Weapons: Intensive Online Introductory Course for Students of Technical Disciplines
“SIPRI and the European Union Non-Proliferation and Disarmament Consortium (EUNPDC) invite graduate and postgraduate students of the technical or natural science disciplines to apply for an intensive online introductory course on chemical and biological weapons—their proliferation, the efforts to eliminate them, the various mechanisms used to control their spread—and endeavours underway to reduce the risk of chemical or biological agents in terrorist attacks. The course will take place online, during four half-days on 28–31 May 2024, 14:00 to 18:00 Central European Summer Time (CEST).”
“The course will cover the fundamentals of chemical and biological weapons as well as of missiles and other means of delivery; the history of chemical and biological warfare; the evolution of international norms against these weapons; the threats associated with potential terrorist uses of chemical and biological material; bioweapons and other related scientific advances; the current challenges posed by chemical weapons; arms control treaties; and mechanisms to curb the spread of dangerous substances, including export controls.”
“The course will also discuss the role of the EU institutions and industry to address the challenges mentioned above. The course will be instructed by renowned experts on non-proliferation, arms control, disarmament, export controls, verification and related subjects from SIPRI, other European research centres, think tanks and international organizations.”
Learn more and apply here.
Registration for GHS 2024 Now Open
Registration is now open for the Global Health Security 2024 conference in Sydney, Australia. This iteration will take place 18-21 June, 2024. The call for abstracts is also still open. “The mission of the Global Health Security conference is to provide a forum where leaders, researchers, policy-makers, and representatives from government, international organisations, civil society, and private industry from around the world can engage with each other, review the latest research and policy innovations, and agree solutions for making the world safer and healthier. To that end, our mission is to help foster a genuinely multidisciplinary community of practice that is committed to working collaboratively to enhance global health security and eliminate disease, irrespective of its origin or source.”
SBA.3 International Synthetic Biology, and Biosecurity Conference in Africa
“Join us for the SBA.3 International Synthetic Biology and Biosecurity Conference in Africa, a groundbreaking event that brings together experts, researchers, and enthusiasts in the field of synthetic biology. This in-person conference will take place at the Laico Regency Hotel from Wed, Jul 17, 2024 to Friday, Jul 19, 2024.”
“Get ready to dive into the exciting world of synthetic biology and explore its potential applications in Africa. From cutting-edge research to innovative solutions, this conference offers a unique opportunity to learn, network, and collaborate with like-minded individuals.”
“Discover the latest advancements, trends, and challenges in synthetic biology through engaging keynote speeches, interactive workshops, and thought-provoking panel discussions. Immerse yourself in a vibrant atmosphere where ideas flow freely and new connections are made.”
“Whether you’re a seasoned professional or just starting your journey in synthetic biology, this conference provides a platform to expand your knowledge, exchange ideas, and contribute to the growth of the field in Africa.”
“Don’t miss out on this extraordinary event that promises to shape the future of synthetic biology and biosecurity in Africa. Mark your calendars and join us at the SBA.3 International Synthetic Biology and Biosecurity Conference in Africa!”
Learn more and register here.

Eighth Annual Next Generation for Biosecurity Competition Open for Applications
“The Eighth Annual Next Generation for Biosecurity Competition is now open. NTI | bio hosts this competition to provide a platform for the next generation of global leaders in biosecurity to develop original concepts and share them with the wider biosecurity community. This year’s co-sponsors include 80,000 Hours, the Global Health Security Network, the iGEM Foundation, the International Federation of Biosafety Associations, the Next Generation Global Health Security Network, Pandemic Action Network, SynBio Africa, and Women of Color Advancing Peace, Security, and Conflict Transformation.“
“This year, the competition invites innovative and creative papers focused on how investments in biosecurity can both contribute to a more equitable society and reduce biological risks. The full prompt is provided below.”
“Winners of the Biosecurity Competition will be awarded the following:
- Online publication of their paper on the NTI website
- The opportunity to attend a high-profile international biosecurity event, such as the Biological Weapons Convention, and present their paper at a prestigious side event.”
Learn more here.
Nonproliferation Review and CNS Announce McElvany Award Winners
“The Nonproliferation Review and the James Martin Center for Nonproliferation Studies (CNS) are pleased to announce that an article examining the George W. Bush administration’s policies toward the nuclear programs of Iran and South Korea, “A tale of two fuel cycles: defining enrichment and reprocessing in the nonproliferation regime” by Sidra Hamidi and Chantell Murphy, has won the Doreen and Jim McElvany Nonproliferation Award’s grand prize.”
“In examining the Bush administration’s policies toward two states with advanced nuclear fuel cycles, Hamidi and Murphy’s article also explores the various US and international definitions of uranium enrichment and spent-fuel reprocessing. Its analysis draws on the concept of “technopolitics,” the study of the mutually reinforcing processes by which political priorities shape technological systems while technology also limits and creates new kinds of politics.”
Read more here.











Summer Workshop on Pandemics, Bioterrorism, and Global Health Security